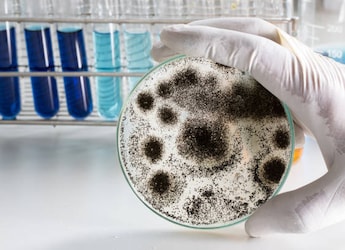
related

Of seven bacterial species linked to higher risk of HIV, the most conspicuous of them is Parvimonas Type 1,
Seven specific bacterial species in high concentrations can increase HIV risk in women
HIGHLIGHTS
- Seven bacterial species can increase HIV risk in women
- Of seven bacterial species, the most conspicuous is Parvimonas Type 1
- The odds of HIV infection increased as concentrations of that bacteria
Scientists have identified seven bacterial species whose presence in high concentrations may significantly increase the risk of HIV infection in women. The findings add strength and precision to a growing body of evidence that the makeup of bacterial communities in the vagina - the vaginal microbiome - may increase or decrease HIV risk for women, depending on which bacteria are there. The researchers from the Fred Hutchinson Cancer Research Center in the US said the results could lead to a better understanding of how biological conditions may promote infection by the virus that causes AIDS, and perhaps offer targets for future prevention research.
Of seven bacterial species linked to higher risk, the most conspicuous of them is Parvimonas Type 1, an otherwise common bug not considered particularly worrisome, according to the study published in the journal The Lancet Infectious Diseases.
However, the researchers found that women carrying high concentrations of that bug had been dealt the equivalent of a bad hand. They had much higher odds - 4.6 to one - of acquiring HIV than those who did not. The study also showed that the odds of HIV infection increased as concentrations of that bacterium increased.
Biologists call this a "dose-dependent response" - the more bugs, the more risk of HIV infection. Three other bacterial species had a similar dose response.
"When we see dose-response effect, it increases our confidence that this is real," said David Fredricks, from the Fred Hutchinson Cancer Research Center.
Gathering this information required a remarkable collaboration involving five of the largest studies of HIV risk carried out in Africa. It involved intensive molecular testing of swab samples from 87 women who had acquired HIV infection and of 262 who did not, and sophisticated analysis comparing the vaginal microbial communities in each of those groups.
The results were consistent throughout Africa, and among three distinctly different groups of women at high risk of HIV infection: pregnant women, sex workers and women who were initially HIV negative but had HIV-positive male partners.
"What this means is that these results are generalisable to many women, at least in sub-Saharan Africa," said Fredricks.
(This story has not been edited by NDTV staff and is auto-generated from a syndicated feed.)
DoctorNDTV is the one stop site for all your health needs providing the most credible health information, health news and tips with expert advice on healthy living, diet plans, informative videos etc. You can get the most relevant and accurate info you need about health problems like diabetes, cancer, pregnancy, HIV and AIDS, weight loss and many other lifestyle diseases. We have a panel of over 350 experts who help us develop content by giving their valuable inputs and bringing to us the latest in the world of healthcare.